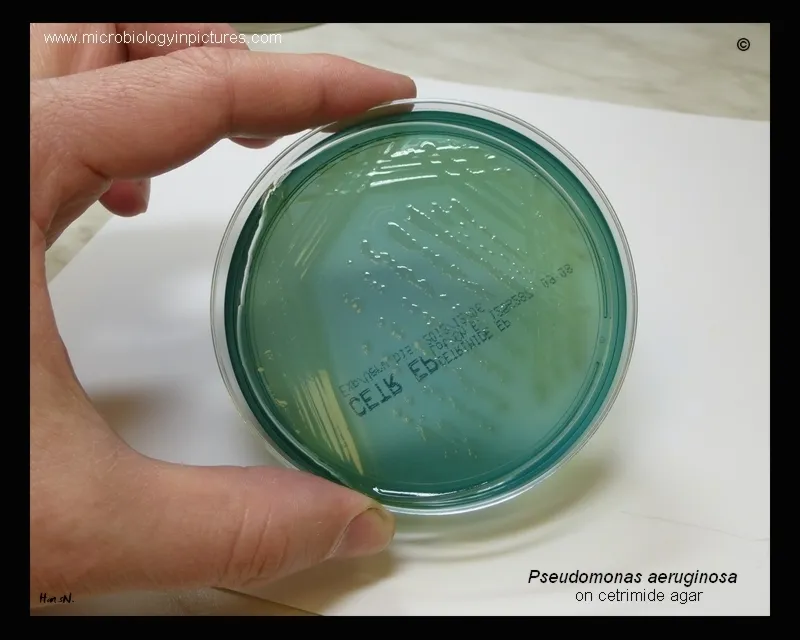
Pseudomonas aeruginosa on cetrimide agar with pyocyanin

Microbiology - The Blue-Green Menace
- Key Features: Gram-negative rod, motile, strictly aerobic.
- Metabolism: Oxidase-positive, non-lactose fermenting.
- Hallmarks: Produces a blue-green pigment (pyocyanin) and has a characteristic grape-like odor.
- Culture: Grows on MacConkey agar.
⭐ It is a notorious opportunistic pathogen, especially in patients with cystic fibrosis, burns, and those who are immunocompromised. It is a common cause of ventilator-associated pneumonia.
📌 PSEUDOMONAS mnemonic: Pneumonia, Sepsis, External otitis, UTIs, Drug use, Osteomyelitis, Meningitis, And Skin infections (hot tub folliculitis).
Virulence Factors - Arsenal of Attack
| Virulence Factor | Mechanism of Action |
|---|---|
| Exotoxin A | Inactivates Elongation Factor 2 (EF-2) via ADP-ribosylation, halting protein synthesis. |
| Phospholipase C | Degrades cellular membranes, contributing to tissue damage and hemolysis. |
| Pyocyanin | Blue-green pigment; generates reactive oxygen species (ROS), impairing ciliary function. |
| Endotoxin (LPS) | Outer membrane component; triggers robust inflammatory response leading to fever & shock. |
| Biofilm | Polysaccharide slime that protects from antibiotics & phagocytosis; crucial in CF & device infections. |
⭐ Exam Favorite: The mechanism of Exotoxin A (ADP-ribosylation of EF-2) is identical to that of Diphtheria toxin.
Clinical Diseases - The Opportunist's Hitlist
P. aeruginosa is a quintessential opportunist, primarily striking individuals with compromised defenses. It's notorious for causing a wide array of infections, especially in hospitalized patients.
📌 Mnemonic: BE PSEUDO
- Burns: A leading cause of infection in burn victims, thriving in the moist, avascular environment of the eschar.
- Endocarditis: Tricuspid valve endocarditis, particularly in IV drug users.
- Pneumonia: The classic pulmonary pathogen in cystic fibrosis patients, leading to bronchiectasis. Also, a major cause of hospital-acquired and ventilator-associated pneumonia (VAP).
- Sepsis: Can cause life-threatening sepsis, often originating from lung or urinary tract infections, especially in neutropenic patients.
- Ecthyma Gangrenosum: Hemorrhagic, necrotic skin lesions pathognomonic for Pseudomonas sepsis.
- UTIs: Complicated urinary tract infections, frequently associated with indwelling catheters.
- Diabetic Osteomyelitis: Chronic bone infection, classically following puncture wounds through footwear in diabetics.
- Otitis: Malignant otitis externa in the elderly and diabetics; "swimmer's ear" and hot tub folliculitis.

⭐ P. aeruginosa is the most common cause of ventilator-associated pneumonia (VAP), a critical consideration for patients on mechanical ventilation in the ICU.
Treatment - The Resistance Fight
P. aeruginosa is notorious for its multi-drug resistance (MDR), often requiring combination therapy guided by local sensitivity data.
| Drug Class | Key Anti-Pseudomonals |
|---|---|
| Penicillins | Piperacillin-tazobactam |
| Cephalosporins | Ceftazidime, Cefepime |
| Carbapenems | Meropenem, Imipenem |
| Monobactams | Aztreonam |
| Fluoroquinolones | Ciprofloxacin |
| Aminoglycosides | Gentamicin, Tobramycin |
- A ubiquitous Gram-negative rod, it is oxidase-positive and thrives in aquatic environments.
- It is a classic opportunistic pathogen, causing severe disease in patients with cystic fibrosis, burns, and neutropenia.
- Key clinical syndromes include hot tub folliculitis, malignant otitis externa, and ventilator-associated pneumonia.
- It produces a blue-green pigment (pyocyanin) and a characteristic grape-like odor.
- Its major virulence factor is Exotoxin A, which inhibits protein synthesis by inactivating EF-2.
- Notoriously multidrug-resistant.
Unlock the full lesson and continue reading
Signup to continue reading this lesson and unlimited access questions, flashcards, AI notes, and more